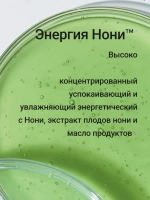
Набор с микроиглами и ретинолом Увлажнение Vita-A
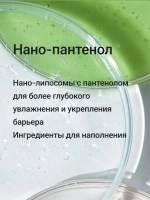
Набор с микроиглами и ретинолом Увлажнение Vita-A

Описание
Набор из сыворотки CELIMAX The Vita-A Retinol Shot Tightening Serum (30 мл) и бустер-крема CELIMAX The Vita-A Retinol Shot Tightening Booster (15 мл) с ретинолом и микроиглами (спикулами). Восстанавливающая сыворотка с экстрактом нони Celimax The Real Noni Energy Ampoule10 мл
Оказывают лифтинг-эффект, предотвращают птоз тканей, поддерживают их тонус, сокращают статические и мимические морщины, уменьшают их глубину;
при регулярном использовании средства разглаживает микрорельеф - уменьшают размер и глубину пор за счёт повышения упругости и эластичности;
Ретинол (0,1%) стимулирует обновление на клеточном уровне, активизирует выработку коллагена и эластина. Cнижает риск развития акне, уменьшения размера и глубины пор и разглаживания морщин.
A-ShotTM — обеспечивает доставку активно действующих компонентов в глубокие слои эпидермиса и стимулирует процессы обновления клеток. Оказывает деликатное отшелушивающее действие, способствует сокращению гиперпигментации, выравниванию текстуры кожи.
Matrixyl3000 (3%, Palmitoyl Tripeptide-1, Palmitoyl Стимулирует обновление на клеточном уровне, укрепляет внеклеточный матрикс, повышает синтез коллагена и гиалуроновой кислоты, тем самым подтягивает и разглаживает кожу, моделирует овал лица и восстанавливает упругость.
Аскорбиновая кислота — нестабильная форма витамина C, которая оказывает наиболее мощное осветляющее и антивозрастное действие.
Ниацинамид (витамин B3) способствует стимуляции синтеза коллагена и улучшению защитных функций, помогает снизить трансэпидермальную потерю влаги и устранить пигментацию.
Пантенол (1%, витамин B5) восстанавливает целостность рогового слоя
Восстанавливающая сыворотка с экстрактом нониCelimaxThe Real Noni Energy Ampouleувлажняет и смягчает кожу, снижает реакцию на внешние раздражители, успокаивает зуд и чувство стянутости, укрепляет естественный защитный барьер. Комплекс антиоксидантов в составе оказывает антивозрастной эффект.
Характеристики
Бренд
Celimax
Страна производства
Республика Корея
Состав
Вода (Water),
глицерин (Glycerin),
Бутиленгликоль (Butylene Glycol),
1,2-Гександиол (1,2-Hexanediol),
Каприловый/каприновый триглицерид (Caprylic/Capric Triglyceride),
Ниацинамид (Niacinamide),
Диизостеарилмалат (Diisostearyl Malate),
Пантенол (Panthenol),
Цетеарилоливат (Cetearyl Olivate),
Цетеарилглюкозид (Cetearyl Glucoside),
Сорбитаноливат (Sorbitan Olivate),
лецитин (Lecithin),
Карбомер (Carbomer),
Аргинин (Arginine),
Токоферол (Tocopherol),
Ретиналь (0,1%) (Retinal (0.1%)),
ксантановая камедь (Xanthan gum),
Этигексилглицерин (Ethylhexylglycerin),
Аденозин (Adenosine),
Изостеарат сорбитана (Sorbitan Isostearate)
Действие
против пигментации,
омолаживание,
сужение пор
Назначение косметического средства
для лица,
для тела,
для шеи и декольте
Срок годности
3 года с даты производства
Форма упаковки
Туба
Упаковка
туба
Объем товара
55
Комплектация
сыворотка с ретинолом и микроиглами,
крем бустер с ретиналем и микроиглами
Дата окончания действия сертификата/декларации
12.02.2029
Номер декларации соответствия
ЕАЭС N RU Д-KR.РА01.В.92858/24
Дата регистрации сертификата/декларации
14.02.2024
Повод
новый год,
день учителя,
1 сентября
Назначение подарка
любимой,
маме,
косметический набор
ТНВЭД
3304990000
ТН ВЭД коды ЕАЭС
3304990000 - Прочие косметические средства или средства для макияжа и средства для ухода за кожей (кроме лекарственных), включая средства против загара или для загара; средства для маникюра или педикюра
Ставка НДС
Без НДС
Артикул
Celimax_набор_с_нони
Особенности косметики
корейские бренды
Отзывы
Отзывов еще никто не оставлял
Выбрать